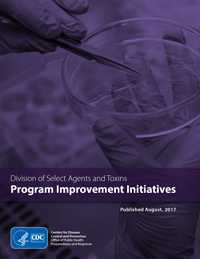

Division of Select Agents and Toxins: Progress Towards Change
The information below draws from and summarizes the recommendations relevant to CDC’s role within the Federal Select Agent Program (FSAP). This resource is designed to:
- Collect the recommendations in one place
- Outline actions that have been identified to address each one
- Provide an update on progress towards implementation
The Division of Select Agents and Toxins (DSAT), in conjunction with its Agriculture Select Agent Service (AgSAS) colleagues, continues to work diligently to make these improvements and will provide periodic updates to this page as the initiative progresses.
A PDF version of this summary (released in August 2017) is
available here.
Improving Inspections
Improving Facility Inspections
Improve quality and consistency of FSAP inspections, inspection teams, and inspectors
ACTION TAKEN:
- Identify violations that require greater inspector judgment and establish an inspector training plan to address knowledge gaps and increase standardization so that registered entities have clear, consistent information
- STATUS: Ongoing; observations requiring greater inspector judgment have been identified, and internal efforts to develop trainings, as well as train inspectors, on these issues are underway
- ADDRESSES:
- CDC 90-Day #1: Reduce potential variability of inspections
- FTAC #7: Improve consistency of inspections
- Create a set of examples that categorize violations along a spectrum of severity which can then be used to ensure enforcement actions are appropriate given the violation severity; this will serve to increase compliance by reducing ambiguity and providing more precise and transparent information to the regulated community on how performance and violations are graded
- STATUS: In progress; violations have been categorized according to a range (or spectrum) of severity, along with enforcement options; FSAP shared this with the regulated community for feedback in June and October 2016. In addition, FSAP has convened external panels to review and provide feedback. DSAT is currently piloting this approach to ensure consistency in inspection findings.
- ADDRESSES:
- CDC 90-Day #1: Reduce potential variability of inspections
- CDC 90-Day #4: Better characterize severity of inspection findings
- CDC 90-Day #5: Prioritize and strengthen enforcement actions to highest risk violations
- FTAC #9: Categorize inspection findings
Analyze inspection data and risk assessments to prioritize oversight activities
ACTION TAKEN:
- Examine and convey trends and associations between inspection findings and risk in order to better understand and anticipate actions most strongly and most often associated with poor outcomes; use this information to improve biosafety and biosecurity practices across regulated entities and improve the inspection process
- STATUS: In progress; data analysis is underway
- ADDRESSES: CDC 90-Day #7: Analyze trends and associations between inspection findings and risk
- Review the science and practice of risk assessment in modern select agent laboratories to identify the highest risk activities; this will inform additional recommendations to implement standardized risk assessment activities and improve the effectiveness and timeliness of the inspection process
- STATUS: Completed; an independent external group conducted this review and developed a report to help inform FSAP activities moving forward.
- ADDRESSES: CDC 90-Day #3: Review and implement options for standardized risk assessment
Increase inspection capacity
ACTION TAKEN:
-
Develop a staffing and retention plan for inspectors to improve the FSAP’s ability to effectively conduct an increased volume of inspections, as well as limit turnover of trained, experienced staff
- STATUS: Ongoing; an internal report of DSAT staffing, recruitment, training, and retention was completed in June 2016 and work to implement improvements is underway
- ADDRESSES: CDC 90-Day #2C: Present staffing and retention plans
Address inventory control concerns
ACTION TAKEN:
- Clarify current FSAP policy regarding the monitoring of inventories, to ensure clear and consistent understanding of the policy across inspectors and entities
- STATUS: Completed and communicated policy to registered entities on 2/23/16
- ADDRESSES: FTAC #6: Retain inventory control requirements
Improving Inspection Reporting
Improve content and clarity of inspection reports
ACTION TAKEN:
- Design and implement a system to better characterize the overall severity of inspection findings to reduce ambiguity and increase understanding in the regulated community on how performance and violations are graded
- STATUS: In progress; a pilot program of the categorization system for severity is underway and the tool is being refined in response to lessons learned. This information will be used by DSAT to generate inspection report cards to summarize the entity’s regulatory departures following an inspection and show how its performance compares relative to other entities; sample inspection report cards were developed and shared with the regulated community for feedback in June 2016. DSAT report card pilot began in October 2016 and lasted for approximately six months. Following an evaluation period, DSAT intends to resume issuing inspection report cards.
- ADDRESSES:
- CDC 90-Day #4: Better characterize severity of inspection findings
- CDC 90-Day #5: Prioritize and strengthen enforcement actions to highest risk violations
- CDC 90-Day #7: Analyze trends and associations between inspection findings and risk
- FTAC #9: Categorize inspection findings
- Establish an inspection report auditing process to assess the overall quality and tone of inspection reports to improve content and consistency on a sample of inspection reports
- STATUS: Ongoing; lessons learned will help to inform additional program efforts
- ADDRESSES: CDC 90-Day #1: Reduce potential variability of inspections
- Assess the range of terminology currently used in inspection reports in order to develop clear and consistent standard language for use
- STATUS: Ongoing; inspection report templates and a database of standard language that can be used by inspectors to aid in the preparation of inspection reports have been developed and will continue to be refined over time
- ADDRESSES: CDC 90-Day #1: Reduce potential variability of inspections
Improve the timeliness of inspection reports
ACTION TAKEN:
- Implement a process to issue interim inspection reports to entities to provide timely feedback after an inspection, particularly when a final inspection report will not be completed within 30 business days. These can be one of two types: 1). Routine preliminary reports that are for an entity’s information only, and 2). Immediate action preliminary reports that highlight serious violations needing urgent action
- STATUS: Completed; implementation remains ongoing
- ADDRESSES:
- CDC 90-Day #2B: Provision of interim inspection reports
- FTAC #8: Improve customer service
- Initiate routine analysis and reporting of inspection report timeliness data to identify opportunities to improve issuance of final reports within 30 days after an inspection
- STATUS: Completed; An external report analyzing inspection report timeliness throughout 2015 was published on 4/20/2016 (available here) and DSAT intends to issue these reports on an annual basis moving forward. The 2016 report is also available here.
- ADDRESSES:
- CDC 90-Day #2A: Increase timeliness of inspection reports
- FTAC #8: Improve customer service
Improving Customer Service
Provide opportunity for entities to give inspection feedback
ACTION TAKEN:
- Develop survey so that registered entities can provide feedback on the inspection process, including on the consistency of inspections, following the conclusion of a renewal, verification, or amendment inspection.
Provide opportunity for entities to request interpretations of the select agent regulations
ACTION TAKEN:
- Establish a formal mechanism for issuing, publicizing, and accepting entities’ requests for FSAP to answer questions regarding the select agent regulations
- STATUS: Completed and communicated the process to regulated entities on 12/29/15
- ADDRESSES: FTAC #1: Accept requests for regulation interpretation
Increase opportunities for the select agent community to provide program input
ACTION TAKEN:
- Share draft FSAP policies and guidance before these items are finalized (as appropriate) to allow the community to provide input into issues that will affect their work
- STATUS: Completed; implemented as of January 2016
- ADDRESSES: FTAC #8: Improve customer service
Provide opportunity for entities to dispute findings in inspection reports
ACTION TAKEN:
Increase ease of ability for those in the regulated community to move from one institution to another
ACTION TAKEN:
- Work with FBI/CJIS to create a process so that individuals with current approved security risk assessments (SRA) completed at one entity can move to another without having to undergo a second SRA
- STATUS: Completed; implemented as of July 2016. For those with a current approved SRA, the process allows visitors, transferring personnel, and personnel who work at more than one entity to work without having to undergo an additional SRA at the second entity.
- ADDRESSES:
- FTAC #4: Individual-based Security Risk Assessments
Provide additional training and guidance to the select agent community
ACTION TAKEN:
- Develop guidance for Customs and Border Protection (CBP) inspectors that process shipments of select agent and toxins coming into the U.S. to increase awareness of the applicable regulations
- STATUS: Completed guidance on 1/14/16; currently working with CBP on implementation.
- ADDRESSES: FTAC #13: Develop training and guidance for customs inspectors
- Establish a training program for entities’ Responsible Officials (ROs) in order to increase education and build community
- STATUS: Completed; the first multi-day in-person FSAP workshop for Responsible Officials was held December 6-8, 2016 in Riverdale, MD.
- ADDRESSES: FTAC #3: Peer-sharing of best practices
- Strengthen guidance for ROs to encourage participation in their entities’ biosafety and biosecurity oversight committees so that the ROs are engaged in discussions affecting the work
- STATUS: Completed; an updated resource manual for ROs was published by FSAP on 3/21/17 and is available here.
- ADDRESSES: FESAP #2.3: Optimize guidance for ROs
- Establish and update guidance for entities on biosafety and biosecurity plan development to provide additional details and clarity on what is needed to comply with the select agent regulations and increase biosafety and biosecurity measures
- STATUS: Completed:
- Published amendments to the select agent regulations include specific requirements for drills and exercises (FESAP #2.1; Completed on 1/19/17)
- A new guidance document on developing biosafety/biocontainment plans was published by FSAP on 3/21/17 (available here), and a template to assist in development was published on 5/16/17 (available here).
- Message was sent to regulated entities to communicate the importance of entities establishing policies on maximum work hours for those in high containment laboratories (FESAP #2.7; Completed on 4/5/16)
- ADDRESSES:
- FESAP #2.1: Add requirements for drills and exercises
- FESAP #2.6: Improve guidance for biosafety plans
- FESAP #2.7: Amend guidance documents to consider maximum work hour policies
- STATUS: Completed:
- Update and improve guidance for entities on inventory management best practices
- STATUS: In progress
- ADDRESSES:
- FESAP #1.8: Improve material accountability practices and procedures
- FESAP #2.5: Improve guidance regarding working stocks and inventory control
- FTAC #6: Retain inventory control requirements
- Increase awareness of the OIG hotline so that staff at registered entities know how to anonymously report a safety or security concern
- STATUS: Completed:
- Added hotline information to the FSAP website
- Published amendments to the select agent regulations contain a specific requirement for entities to provide staff training on how to access the hotline
- ADDRESSES: FESAP #2.2: Add OIG hotline training requirement
- STATUS: Completed:
Improve information systems
ACTION TAKEN:
- Develop a new electronic information system that will increase efficiency, accuracy, and speed of interactions between FSAP and registered entities
- STATUS: In progress
- ADDRESSES: FTAC #8: Improve customer service
Keep pace with scientific advances in the area of diagnostics
ACTION TAKEN:
- Research diagnostic options used to confirm the presence of a select agent, including the incorporation of molecular diagnostic methods in addition to traditional culture-based methods, to keep pace with the current state of the science
- STATUS: Ongoing
- ADDRESSES: CDC 90-Day #9: Keep pace with scientific advances through incorporation of molecular diagnostics
Maintain close communication and coordination with AgSAS colleagues
ACTION TAKEN:
- In conjunction with AgSAS colleagues, develop joint FSAP plans and policies for program improvements, including efforts such as joint inspection reports, regulatory interpretations, the inspection dispute resolution process, and aggregate reporting of data, among others, to ensure collaboration and consistency across the FSAP
- STATUS: Ongoing; routine communication and coordination between agencies continues to take place, including regularly scheduled in-depth discussions each week to discuss issues affecting the program.
- ADDRESSES: Multiple recommendations across the CDC 90-Day, FTAC, and FESAP reviews
Improving Incident Response
Improve entity incident reporting and data collection
ACTION TAKEN:
- Update Form 3 so that incident reporting is more informative about the actual and potential risk of reported theft, loss, and release incidents. This includes identifying the most common categories of incident reports and additional subcategories that are needed to collect a greater level of detail on each reported event in a more consistent fashion.
- STATUS: In progress; FSAP has proposed revisions to Form 3 and the accompanying guidance document. The changes must be approved by OMB before they can officially be implemented.
- ADDRESSES: CDC 90-Day #8: Make reporting more informative about risk of reported incidents
Ensure adequate emergency response capabilities
ACTION TAKEN:
- Review existing regulations to ensure that the emergency authorities of the HHS Secretary are adequate for timely response to domestic or foreign public health emergencies involving select agents or toxins
- STATUS: Completed March 2016; the HHS Biosafety and Biosecurity Council reviewed and concluded that current waiver authorities are adequate; FSAP will continue to be attentive for potential scenarios where current authorities might fall short.
- ADDRESSES: FTAC #5: Develop mechanism for response to emergency situations
Improving Transparency and Engagement
Public release of annual data reports
ACTION TAKEN:
- Assess the feasibility of releasing a public report containing FSAP aggregate data on registered entities, inspection findings, and other key statistics. This includes creating a deliberative process to consider the security implications of such information disclosures.
- STATUS: Completed; a full report containing aggregate data providing insight into work with select agents and toxins at laboratories across the nation, as well as the regulatory functions of FSAP, was issued on 6/30/2016 (materials including the full report and an infographic highlighting key findings are available here. FSAP intends to publish a similar report on an annual basis. The security community was engaged during the development of the report to evaluate and address any potential security concerns associated with the public sharing of the information within the report.
- ADDRESSES:
- CDC 90-Day #10: Increase public reporting of inspection processes and findings
- FTAC #2: Support public release of information
Engagement with the international community
ACTION TAKEN:
- DSAT should support the International Expert Group for Biosafety and Biosecurity Regulation and, through this group, collaborate on related biosafety and biosecurity issues with foreign governments
- STATUS: Completed; DSAT already supports this group, as well as other global work, through its international program efforts
- ADDRESSES: FTAC #12: Engagement with international community
Identify regulatory process alternatives
ACTION TAKEN:
- Research enforcement options used by other U.S. regulatory programs (e.g. aviation, food industry)
- STATUS: Completed; an independent external group conducted this review and developed a report to help inform FSAP activities moving forward.
- ADDRESSES: CDC 90-Day #6: Report on other approaches to increase regulation compliance
Support information-sharing among peers
ACTION TAKEN:
- Establish an independent forum to encourage routine peer-to-peer sharing regarding best practices among those working with select agents and toxins
- STATUS: Completed; ABSA International is providing an online discussion forum, in-person workshop, and webinars for the regulated community to share information and best practices independent of the FSAP. FSAP will provide ongoing support as needed.
- ADDRESSES: FTAC #3: Peer-sharing of best practices
- Page last reviewed: August 8, 2017
- Page last updated: August 8, 2017
- Content source:


 ShareCompartir
ShareCompartir